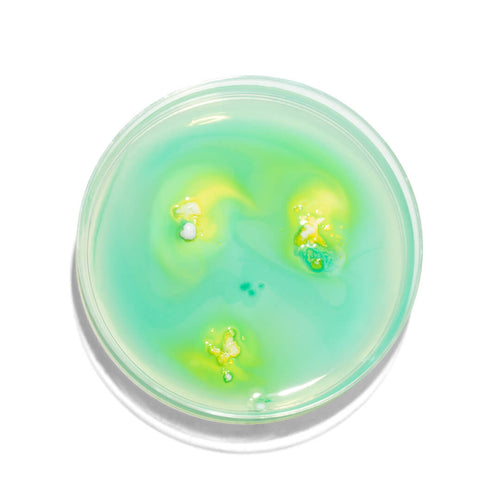

Biotic⁺















Got a discount code? Add it in the next step.
4.8/5 based on 8,925 reviews



For boosted energy, add Vitals⁺ to Magnesium⁺



For lasting energy, take Vitals⁺ with Hydrate⁺



For more energy, try Vitals⁺ alongside Biotic⁺
Your health is worth more than empty words and loose claims.
We research and test every single ingredient. In an industry where others don’t.


We’re committed to evidence-based development.
So you get everything you need, and nothing you’d rather not think about.
Bioavailable, active ingredients
Clean, and vegan, formulas
Smarter capsule
technology
Researched and tested by experts
GLUTEN
GMOs
DAIRY
ANIMAL BY-PRODUCTS
FILLERS
ALLERGENS
CONTAMINANTS
ADDITIVES
TOXINS
HEAVY METALS

Contributes to normal psychological function and energy production. Supports the nervous system and heart.
Known for...
Benefitting plant-based diets (most B1 comes from animal sources).

Helps maintain normal vision, immune function and skin.
Known for...
Working with all immune-boosting nutrients, and B2 for eye health.
Prevalent in the intestines of breastfed infants, suggesting their importance in early immune development.

Contributes to the reduction of tiredness and fatigue, normal energy production, and normal iron metabolism.
Known for...
Benefitting plant-based diets (most B2 comes from animal sources).

Part of the emerging field of psychobiotics being studied in the mental wellbeing field.

Helps maintain normal skin. Contributes to normal energy production, and nervous and psychological functions.
Known for...
Benefitting plant-based diets (most B3 comes from animal sources).

Contributes to normal blood formation and immune system functioning, and the reduction of tiredness and fatigue.
Known for...
Working with folic acid, iron and B12 which can protect from anaemia.

Contributes to normal energy metabolism, adrenal function and mental performance.
Known for...
Converting food into energy and forming red blood cells.

Contributes to normal red blood cell formation, and neurological and psychological functions.
Known for...
Helping the body uses folic acid effectively to produce DNA.

Supports normal psychological function. Contributes to normal functioning of the nervous and immune systems.
Known for...
Producing haemoglobin with iron (so it’s important to get both).

Maintains hair and skin. Supports normal macronutrient metabolism and functioning of the nervous system.
Known for...
Its benefits to hair, skin, and nail health (aka the "beauty vitamin").

Contributes to the normal function of the immune system and collagen formation, and increases iron absorption.
Known for...
Improving the body’s absorption of iron.

Contributes to normal calcium absorption, which supports the maintenance of bones, teeth and and muscles.
Known for...
Increasing blood levels of vitamin D twice as much as D2.

Contributes to normal immune system functioning. Supports the maintenance of teeth, hair, skin and nails.
Known for...
Being fat-soluble, so your body can store it for future use.

Contributes to normal brain and heart function, and the maintenance of normal blood pressure and vision.
Known for...
Developing the nervous system in pregnancy and early childhood.

Contributes to normal heart function and blood pressure levels.
Known for...
Maintaining blood triglyceride levels key to heart health.

Contributes to normal macronutrient metabolism and maintaining normal blood glucose levels.
Known for...
Working with B vitamins for energy release.

Contributes to normal formation of red blood cells and haemoglobin, and the reduction of tiredness and fatigue.
Known for...
Being enhanced by vitamin C (fruit and veg can optimise absorption).

Contributes to normal energy-yielding metabolism, cognitive function and thyroid hormone production.
Known for...
Working with B vitamins, particularly by those on plant-based diets.

Contributes to protecting cells and DNA from oxidative damage. Supports normal thyroid and immune function.
Known for...
Working well with iodine for thyroid function.

Contributes to normal immune function, cognitive function, fertility and reproduction.
Known for...
Supporting child mental health if parents get enough during pregnancy.

Helps with synaptic growth, and contributes to protecting cells from premature ageing.
Known for...
Being powerful anthocyanins, which give blueberries their blue colour.

Incredibly adaptable strains that can survive in harsh conditions, like the acidic environment of the stomach.

Part of the emerging field of psychobiotics being studied in the mental wellbeing field.

One of the most extensively studied probiotic strains, renowned for its broad health benefits.

Has fermentative properties that are beneficial to health and enhancing fermented foods in the food industry.

First isolated from lychee and mangosteen in SE Asia, where tea from these fruits managed cholera symptoms.

Contributes to normal cognitive function, immune function, heart function and metabolism.
Known for...
Being key to the integrity of the intestinal lining and the immune response.

Plays a key role in over 300 bodily functions, maintaining normal health.
Known for...
Being better absorbed by your body and kinder to your gut.
We pride ourselves on thorough research and choose only the most bioavailable compounds. So you get high-quality, active ingredients, all backed by the latest science.
No fluff, filler or fads.
In an industry that’s poorly regulated, we exceed legal requirements—because the bare minimum isn’t good enough.
All our products undergo thorough research and testing before they hit the market.
Trust goes beyond what’s printed on the label. We make sure our supplements are not only scientifically sound (through research and third-party testing), but also consumer-approved.
Like life, science changes. We review the latest literature, conduct trials, and share our findings.
Keeping a close eye on modern health standards to make sure our formulas stay ahead of the curve.




Supplement brands aren't legally required to have any medical input on the design of their products. We work with Dr Tara Swart, PhD and Sophie Medlin, RD to formulate every supplement.
Designed for maximum absorption, so you can take on an empty stomach without compromising efficacy.
Designed for maximum absorption, so you can take on an empty stomach without compromising efficacy.
Double-barrier, delayed release capsules, so ingredients survive stomach acid and reach the right places.
Double-barrier, delayed release capsules, so ingredients survive stomach acid and reach the right places.
From dietitians to neuroscientists, we work with leading minds and experienced researchers at the very top of their game.
So you can be at yours.









MD, PhD
Science Advisor | MIT Sloan
RD
Head of Nutritional Research | City Dietitians
PhD, MRSB
Director of Science & Research | Heights
Physiologist
Chief Wellbeing Officer | Heights
PhD, RD, BSc
Professor of Nutrition and Dietetics | Ulster University
BSc, PhD, DSC
Professor of Applied Physiology | University of Exeter
PhD, MSc, FRSC, CChem, CSci
Consultant Clinical Scientist & Honorary Senior Clinical Lecturer / Synnovis, St Thomas' Hospital
MBBS (Hons), MPH, MD, DNHE, RNutr
Professor of Global Nutrition & NNEdPro Chief Scientist
PhD, BSc
Professor of Nutrigenetics| UEA Medical School

MD, PhD
Science Advisor | MIT Sloan

MD, PhD
Science Advisor | MIT Sloan
Dr. Tara Swart was with Heights from day 1, formulating our market-leading products.
She's an Oxford-trained medical doctor, neuroscientist with a PhD in neuropharmacology, and former Chief Science Officer at Heights.
She is Senior Advisor for Neuroscience and Leadership at MIT Sloan, an executive advisor to global organisations, and the author of the international bestseller “The Source”.
Recognised for her expertise in applying neuroscience to leadership and personal development, she helps people build resilience, optimise brain performance, and achieve meaningful transformation.

RD
Head of Nutritional Research | City Dietitians

RD
Head of Nutritional Research | City Dietitians
Sophie Medlin has been at Heights since day 1, responsible for ensuring our formulations have a real-world positive impact on our customers.
She's a consultant dietitian, Chair of the British Dietetic Association for London, and founder of City Dietitians.
She previously spent 8 years working in the NHS before becoming a lecturer in Human Nutrition and Health at King’s College London.
Recognised as an expert in gastrointestinal health, Sophie is a regular media spokesperson on evidence-based nutrition and advises both patients and industry on conditions ranging from IBS to colorectal disorders.
At Heights, she plays a key role in ensuring the quality and effectiveness of the supplements.

PhD, MRSB
Director of Science & Research | Heights

PhD, MRSB
Director of Science & Research | Heights
Dr. Harry Jarrett is a scientist specialising in nutrition and human health, leading research at Heights to develop science-backed formulations that improve nutritional status, health and wellbeing.
He collaborates with universities, innovation hubs, and societies to ensure every product is rigorously tested and evidence-based.
His work has been recognised internationally, earning awards such as the Bronze Medal and Nutrition Society Award at the 2025 STEM for BRITAIN competition.
As a published researcher in leading journals, he also provides expert media commentary and serves as a scientific advisor to the Pernicious Anaemia Society.

Physiologist
Chief Wellbeing Officer | Heights

Physiologist
Chief Wellbeing Officer | Heights
Oliver Patrick is a leading physiologist and expert in lifestyle management with 25 years’ experience in executive health and wellbeing.
Formerly Head of Physiology at Nuffield Hospitals and co-founder of Viavi, he now advises global organisations on advanced health assessment and contemporary wellbeing strategies spanning stress, sleep, mindset and lifestyle.

PhD, RD, BSc
Professor of Nutrition and Dietetics | Ulster University

PhD, RD, BSc
Professor of Nutrition and Dietetics | Ulster University
Professor Mary Ward is a registered dietitian and world-renowned nutrition academic. She’s also a Professor of Human Nutrition at Ulster University’s Nutrition Innovation Centre for Food and Health.
Professor Ward serves as Deputy Director of the Wellcome Trust–Wolfson Northern Ireland Clinical Research Facility. Her research on B-vitamins and disease prevention across the lifespan informs national policy, with over 150 scientific research articles published to date.

BSc, PhD, DSC
Professor of Applied Physiology | University of Exeter

BSc, PhD, DSC
Professor of Applied Physiology | University of Exeter
Professor Andy Jones is a world-leading expert in sports nutrition and applied physiology.
He is Professor at the University of Exeter, Editor-in-Chief of Medicine & Science in Sports & Exercise, and a Fellow of multiple international scientific societies.
His research has shaped elite performance worldwide, advising athletes such as Paula Radcliffe and guiding Nike’s “Breaking2” marathon world record attempt.

PhD, MSc, FRSC, CChem, CSci
Consultant Clinical Scientist & Honorary Senior Clinical Lecturer / Synnovis, St Thomas' Hospital

PhD, MSc, FRSC, CChem, CSci
Consultant Clinical Scientist & Honorary Senior Clinical Lecturer / Synnovis, St Thomas' Hospital
Dr. Agata Sobczyńska-Malefora is a Consultant Clinical Scientist at The Human Nutristasis Unit, St Thomas’ Hospital, and Honorary Senior Clinical Lecturer at King’s College London.
A Fellow of the Royal Society of Chemistry and leading expert on vitamin diagnostics, her research on B-vitamin and homocysteine metabolism has placed her among the world’s top-ranked authorities on vitamin B12 deficiency.

MBBS (Hons), MPH, MD, DNHE, RNutr
Professor of Global Nutrition & NNEdPro Chief Scientist

MBBS (Hons), MPH, MD, DNHE, RNutr
Professor of Global Nutrition & NNEdPro Chief Scientist
Professor Shumone Ray is a licensed medical doctor, registered public health nutritionist, and Professor of Global Nutrition.
He is Executive Director and Chief Scientist at the NNEdPro Global Institute for Food, Nutrition and Health in Cambridge and has held senior research and advisory roles with the University of Cambridge, WHO, and UNICEF.
With over 300 scientific research articles to his name, his contributions continue to advance the field of human nutrition and health.

PhD, BSc
Professor of Nutrigenetics| UEA Medical School

PhD, BSc
Professor of Nutrigenetics| UEA Medical School
Professor Anne-Marie Minihane is Head of Nutrition and Preventive Medicine at Norwich Medical School.
She is a leading expert in fatty acids and healthy ageing, and she serves on multiple international nutrition journal boards. In addition, she represents the UK in the Federation of European Nutrition Societies global initiative developing the CONSORT-Nutrition Framework.
Meet your new healthy habits. No 4am starts or green sludge necessary.
 Multivitamin
Multivitamin
20 key nutrients to fuel your body and feed your brain
 2x capsules
30 day supply
2x capsules
30 day supply
 Magnesium
Magnesium
Magnesium glycinate to power 300+ bodily functions
 2x capsules
30 day supply
2x capsules
30 day supply
 Probiotic
Probiotic
7 high-impact bacteria strains + zinc, proven to go further
 1x capsule
30 day supply
1x capsule
30 day supply
 Multivitamin
Multivitamin
20 key nutrients to fuel your body and feed your brain
 2x capsules
30 day supply
2x capsules
30 day supply
 Magnesium
Magnesium
Magnesium glycinate to power 300+ bodily functions
 2x capsules
30 day supply
2x capsules
30 day supply
 Probiotic
Probiotic
7 high-impact bacteria strains + zinc, proven to go further
 1x capsule
30 day supply
1x capsule
30 day supply











